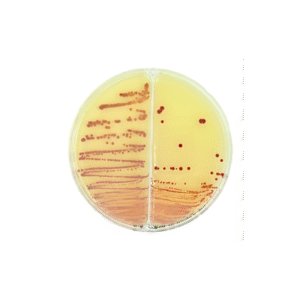
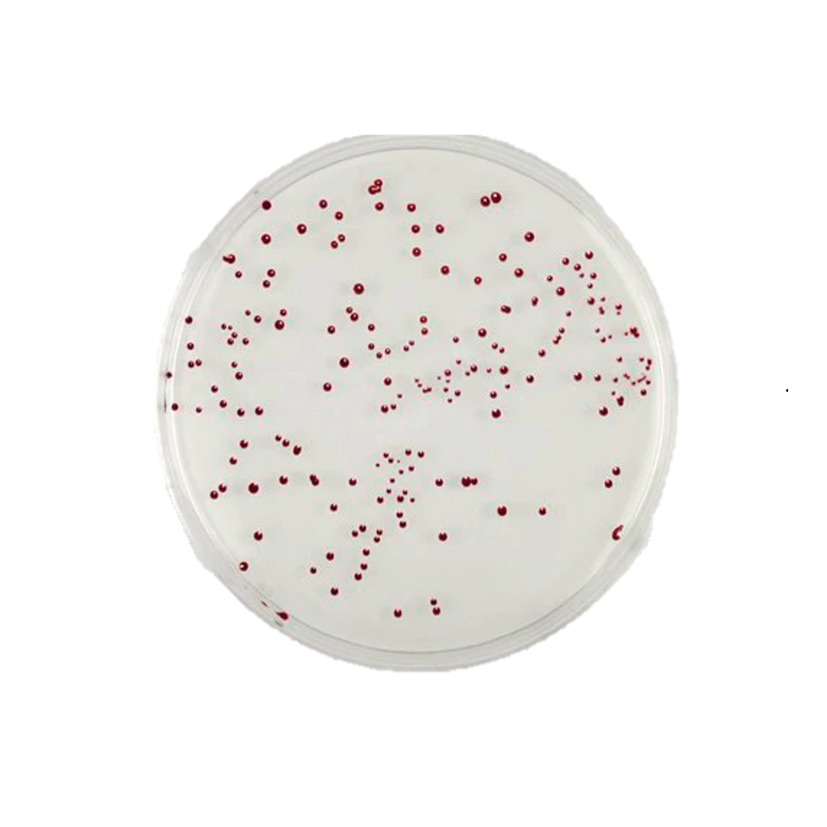
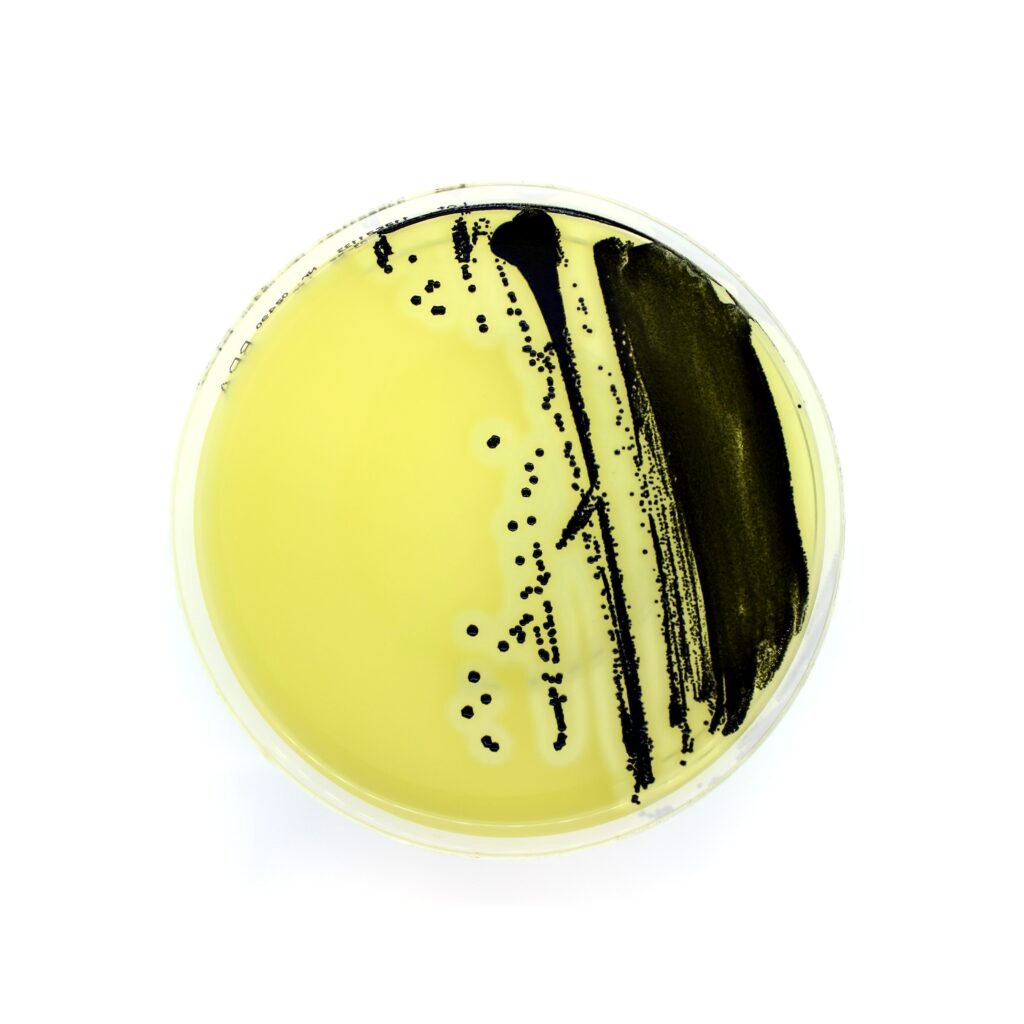
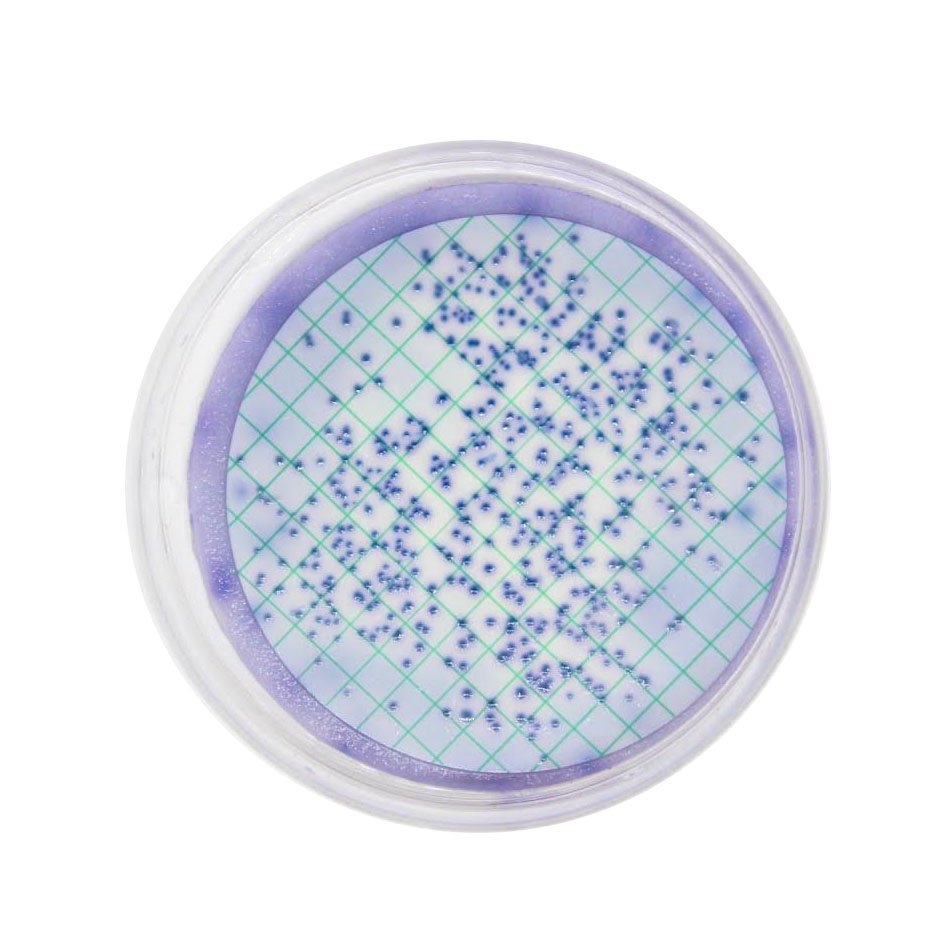
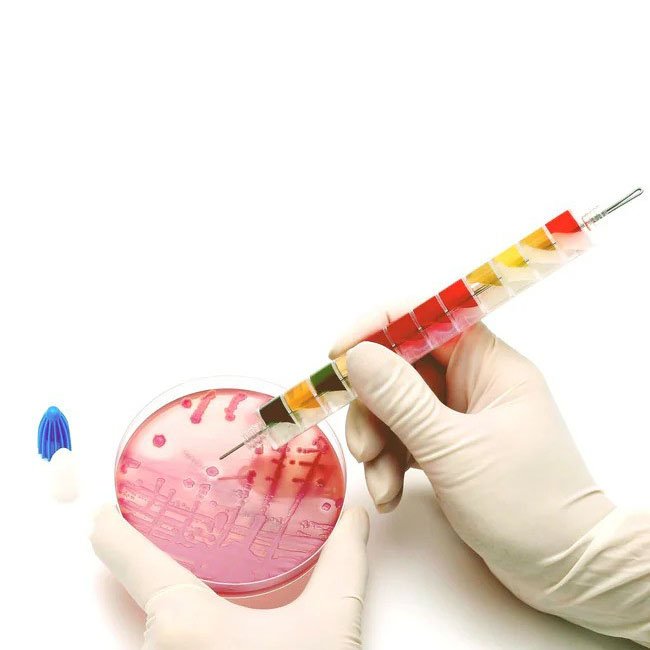

Product Liofilchem
Here are groups of our main products:

The Liofilchem products for clinical and industrial microbiology. Our catalog comprises over 3000 items, mainly classifiable into two categories, clinical and industrial microbiology. Liofilchem produces devices for microbial identification and antimicrobial susceptibility testing, MIC Test Strip, antibiotic discs in cartridges, ready to use culture media in petri dish, tube, bottle and dip-slide, dehydrated culture media, selective supplements, systems for the chemical and microbial screening in food, bio-indicators for the sterilization process control. Liofilchem also produces custom products according to the customer’s specifications.
Contact Us
(+62) 812-5888-7005